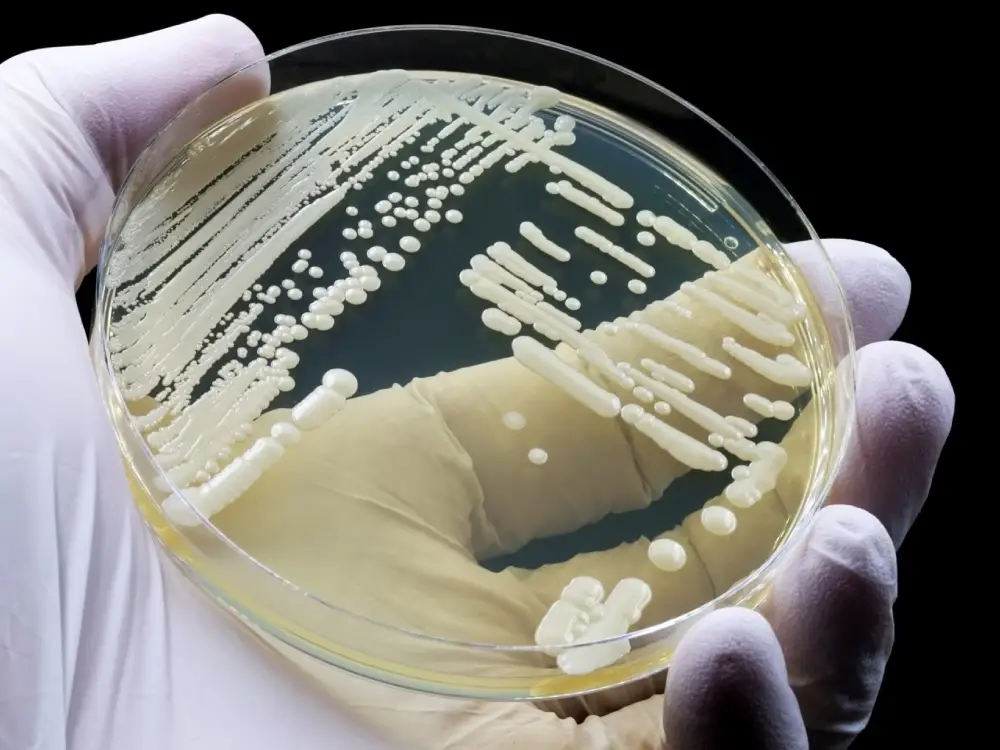
Süper Dirençli Mantar: Avrupa ve Avusturya’da Hızla Yayılıyor

Candidozyma auris, son derece bulaşıcı ve dirençli bir mantar olarak kabul ediliyor. Bu patojen artık Avrupa’da ve hatta Avusturya’da da yayılmış durumda. Sorun şu: Pek çok anti-pilz-mittel (anti-mantar ilacı) bu mantara karşı etkili değil.
Temel olarak mantarlar alışılmadık bir şey değildir – vücudumuzun içinde ve dışında birçok mantar bulunur. Ancak sorunlu durumlar yalnızca bazı türlerde ortaya çıkar; örneğin hautpilze (deri mantarları), hefen (mayalar) ve bazı schimmelpilze (küf mantarları) gibi. 2019’da Japonya’da keşfedilen Candidozyma auris hızla yayılıyor ve hayatı tehdit edebiliyor. Avrupa Hastalık Önleme ve Kontrol Merkezi’ne (ECDC) göre bu enfeksiyon kıtamızda en çok İspanya, Yunanistan, İtalya ve Romanya’da tespit edildi.
Candidozyma auris nasıl bulaşıyor?
Candidozyma auris insanlardan insana schmierinfektion (bulaşma yoluyla temas) ile geçebiliyor, yüzeylerde uzun süre canlı kalıyor ve temizlenmesi çok zor. Julius-Maximilians-Universität Würzburg’daki Hijyen ve Mikrobiyoloji Enstitüsü Direktörü Oliver Kurzai, basın açıklamasında şöyle diyor:
“En önemli bulaşma yolu, dezenfekte edilmesi zor olan ve birden fazla hastada kullanılan cihazlardır.”
Immunschwache, aufgepasst! – Bağışıklığı Zayıf Olanlar Dikkat!
Bu maya mantarı cilde yerleşebiliyor. Ancak tehlike bağışıklık sistemi zayıf olduğunda ortaya çıkıyor – bu durumda mantar vücuda yayılabiliyor, kan dolaşımına girip kan zehirlenmesine neden olabiliyor. Böyle bir durumda hastaların neredeyse yarısı hayatta kalamıyor.
Risk grubunda yeni ameliyat olmuş kişiler, yaşlılar, prematüre bebekler ve hastalar bulunuyor. Hijyenzentrum Bioscientia Direktörü Georg-Christian Zinn RTL’de yaptığı açıklamada şunları aktarıyor:
“Bunlar bağışıklığı baskılanmış hastalar; kanser hastaları, yeni ameliyat olanlar, kronik hastalığı olanlar, örneğin böbrek diyalizi gerekenler.”
Doğru el hijyeni hayati önem taşıyor
Önlemede doğru handhygiene (el hijyeni) en önemli faktör olarak görülüyor. Ancak unutulmaması gereken bir detay var: Her desinfektionsmittel (dezenfektan) bu mantara karşı etkili değil. Özellikle alkollü dezenfektanlar daha verimli kabul ediliyor.